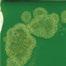
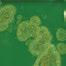
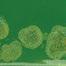
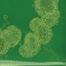
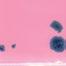
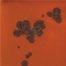
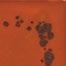
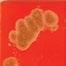
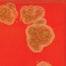
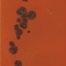
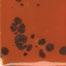
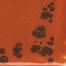
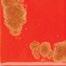
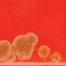
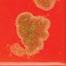
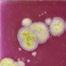
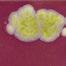
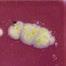
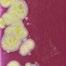
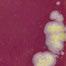
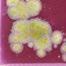
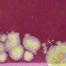
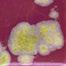

How to Order
Tiles/Trivets
A design as distinctive as you!
Customize any tile glaze or color and add your choice of emblem. All tiles/trivets are 6" x 6" terracotta tile with foam feet for table top display and attached wall hanger for mounting.
Coaster Set
Add a personal touch to your place setting.
Perfect indoors or outdoors, each 4¼" square porcelain tile coaster will add function and fun while entertaining. One design per bundle of four.
Each include felt feet as not to scratch surfaces. Each bundle comes tied in rope twine. (see front cover)
To order, add C after the TT, CT or XT. Example: TTC-700 Be Nice Coasters
Back of Tile
Cover photography by Ethan Keelin
Color Samples
Crafted to be one-of-a-kind, all glazes are hand-applied and color variations add to the unique quality and distinctive nature of each design. No two are alike!
All colors available as solid (without color accents). Indicate name followed by solid when ordering.
Celtic Green Canary Yellow Iris Purple
Cotton Candy Pink Dragon Red
Santa Fe
Sage Green Snow Storm Wild Flower Vibrant Red
Mocha Pumpkin Orange Persian Blue
Light Gray
Antique Yellow Black Ruby Sky Blue Lavender Bright Green
Navel Orange
Wipe Your Paws, Paw Print
TT-635 Paw Print
TT-509 Labrador C
TT-954 Corgi TT-716 Beware of Dog
TT-955 Pitbull
TT-952 Golden Retriever
Shepherd
Ladybug
Crab
Starfish
TT-705 Fish Trout
Dolphin
Seahorse
Atlantic Lobster TT-409 Lobster
Octopus C
Bunny
Deer
Moose
Labradoodles
Squirrel
Dachshund
TT-605 Pandas (two sitting)
Bear C
TT-682 Woof C
Cat (standing)
Cat (sitting)
Meow
Whale
Lighthouse
Anchor
Mermaid
Flamingo
Rooster
Penguins
Scallop
Owl
Whale Tail TT-950 Chicken
Loon (swimming duck)
Horse
Bear Claw
Buffalo
Giraffe
Elephant
Reindeer
Fox
Dragonfly
Spider
Bats
Butterfly
Hummingbird
Egyptian Beetle
TT-461 Rabbit (jumping)
Flowers
Tulip
Poppy Color Orange Flower
TT-054-W Water Lily (White)
TT-151 Rose
TT-146 Lotus
TT-054 Water Lily
TT-053 Sunflower
TT-053-C Sunflower (Choice of Color)
TT-148 Daisy
TT-820 Maple Leaf C TT-149 Edelweiss C
TT-322 Canoe on Lake
TT-088 Canoe Pine Trees
TT-813 Half Dome
Weathervane
C
Birch Trees with Cardinals
Birch Trees
Pine Trees C
Birch Gnomes C
TT-329 Peacock Feather
C TT-323-B Cardinal Pinecones C TT-323-W Cardinal Pinecones
Chickadee
Blue Jay
Robin TT-698 Raven / Crow Bird C
C TT-094 Big Foot
TT-061 Big Foot w/ Gnome
TT-077 Red Mushrooms
C TT-327 Mushrooms
TT-048 Skier
TT-089 Sailboat TT-325 Cardinal C
Around the World
SKAL
Fika
Dala Horse (Red)
Dala Horse (Blue)
Dala Horse (Choice of Color)
TT-530 Uff Da!
Gnome / Tomte
LOVE by Robert Indiana
Ship w/ Circle
Thor’s Hammer
Ship
Head
Viking Ship Outline
Helmet
Big Foot w/ Gnome
Cardinal Pinecones
Cardinal Pinecones
TT-324 Birch Trees with Cardinals
Birch Trees
TT-620 Aquavit C
France Flag
TT-640 Holland Flag
Ireland Flag
Sweden Flag
Flag
Flag
Flag
TT-636 Finland Flag
Iceland Flag
Flag
TT-641 Swiss Flag C TT-961 I Heart Lefse TT-962 OPE CT-053 Dancing Gnome
TT-330 Windmill
CT-002 Windmill Scene CT-073 Gnome with Abelskivers
Danish Heart Red/White
HOTDISH
Love with Dala Horse
Red Mushrooms
Gnome
Hygge
Sisu
Valknut
Viking Compass
TT-052 Pine Trees C
XT-031 Birch Gnomes C
Judaic
Coffee Cup (Pink)
on Wave (Red)
Hamsa
Shalom (Hebrew)
TT-704 Love (Hebrew - Ahava)
Cha’i (Hebrew - Life) C
Shalom Y’all (Hebrew)
Shalom Y’all (English) C
Menorah
Shalom
Dreidle
Star of David XT-012
Happy Passover
Happy Rosh Hashanah
Happy Purim TT-400 Martini Glass
Martini Glasses
TT-714 Margarita Glass
TT-709 Wine Bottle w/ Grapes
TT-697 Bass Clef C
TT-612 Treble Clef C
TT-925 Beer Stein
TT-926 Guitar
Tiki Totem
Tiki Head
Palm Trees
Bicycle
Bike Sign
Mushrooms
Kokopelli Biker
Palm Tree
TT-549-R Coffee Cup (Red)
TT-055 Ruby Slippers
TT-774-C Adirondack Chair (Choice of Color)
TT-774-R Adirondack Chair (Red)
TT-774-B Adirondack Chair (Blue)
TT-823 Boxer
TT-040 Hot Air Balloon C
TT-549-B Coffee Cup (Blue)
TT-549-Y Coffee Cup (Yellow)
TT-549-O Coffee Cup (Orange)
TT-549-P
TT-041-R Surfer
TT-041-B Surfer on Wave (Blue)
TT-041-O Surfer on Wave (Orange)
TT-041-W Surfer on Wave (White)
Services
Sheriff Blue Line Flag
Wipe Your Paws
Scales
Sad Face
Happy Face
Thumbs Down
Snowflakes
Snowman
Bells
Budded Cross
Gnome
Tomte
LOVE by Robert Indiana
Christmas Wreath
Santa Face
Heart Outline
TT-546 Pie Slice
Birch Gnomes
Día de Muertos
Gnome
TT-818 Hard to forget
TT-685 Te acher Forms TT-684 Child Born Grandmother
TT-607 Be The Change TT-686 Leap TT-687 Live, Laugh, Love
Nature Walk Kitchen Heart Home
C TT-542 Imagine
Happiness Coffee
LL Strong Coffee
Family Music
Life Song
Best Wines Friends TT-690 Friendship Wine
TT-694 Child Born Grandparents TT-719 Friends Love you the Same
Memory becomes treasure
Someone we love heaven
Mountains are calling
Beach Calling
TT-823 The more difficult... TT-824 You miss 100%... TT-825 Food is our common...
Don’t Piss Off
Serenity
Dream
Be Kind
Creative ways to use my tiles.
Custom Tiles
Promote your company or celebrate an event with a truely unique, one of a kind tile or coaster with your logo or design. There will be a one time, set-up fee of $100. An electronic proof will be provided for approval. Changes made following your approval, may incur additional set-up or design charges. A physical sample can also be made for an additional fee, please ask for a quote. 50% deposit is required upon electronic proof approval.
Your design or logo must be provided as a high resolution (300 dpi) .psd, .eps or .jpeg file, sized to fit inside a 5.5" x 5.5" frame for tiles or 3.75" x 3.75" for coasters.
We do offer design services at an hourly rate. Whether it’s a simple adjustment or full creative services, we have artists to make your custom order memorable. Please ask.
There are over 15 stock base colors to choose from and 10 color burst options making many color combinations possible. The quantity ordered does not need to be all in the same color. You can select colors any way you like.
Typical production time is 3-4 weeks, however we will ship your order as quickly as we can. We ship ground services using FedEx or UPS. Expedited shipping is available, please ask for a quote.
Customize
Minimum order of 25 6x6 tiles or 50 4x4 coasters (12 sets) with the same design.
Name drops on existing images add $35 set up fee per design.
Commemorate an anniversary, reunion, shower, or wedding day with names and date.
We can customize the label on the back of the tile or coaster. Add your company name or logo.
There will be a one time, set-up fee of $35. Set up fee is waived for Custom Tile or Coasters. A standard print or script font is available on up to three lines of text.
Please ask for more details.